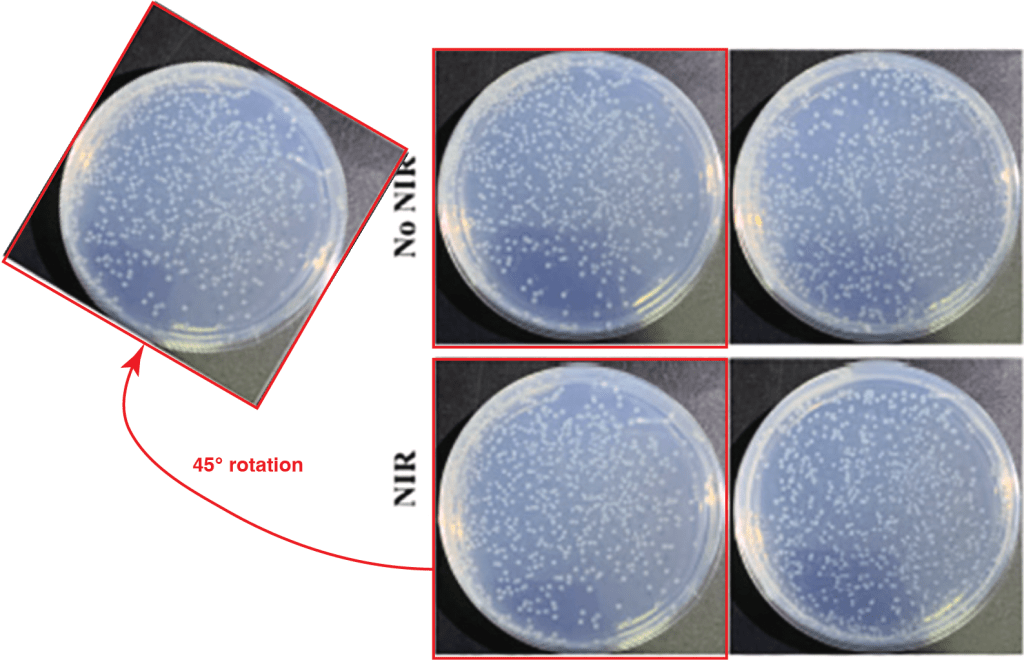

Archasia belfragei is a PubPeer pseudonym of a sleuth, who is still young enough, still in academia, and therefore still hopeful. They still hope that once Elsevier is shown the extent of fake science it makes billions with, the publishing giant will see the errors of its ways, and change.
And then probably Philip Morris and Anheuser-Busch will follow suit and change their business model also.
The sleuth focussed on one Elsevier biochemical journal which is directly connected to a second one via their common Editor-in-Chief, and indirectly to a third journal, which already featured on For Better Science.
Will Elsevier listen to the advice of Archasia belfragei? Or maybe, like with alcohol and nicotine, the scholarly publishing business is only truly profitable when it runs on vice?
And for those in a hurry: there is a spreadsheet.

The Miracle-Polymer-Dumbsterfire
By Archasia belfragei
Carbohydrate Polymers (Impact factor 10.7) is one of many Elsevier journals dedicated to polymer science, with a research scope statement that basically states: If you work on polymers, publish with us!
“Carbohydrate Polymers is a major journal within the field of glycoscience, and covers the study and exploitation of polysaccharides which have current or potential application in areas such as bioenergy, bioplastics, biomaterials, biorefining, chemistry, drug delivery, food, health, nanotechnology, packaging, paper, pharmaceuticals, medicine, oil recovery, textiles, tissue engineering and wood, and other aspects of glycoscience.”
Aims & Scope
2010 saw a mere 643 papers published (pff, beginner numbers). The printing press has been speeding up and is now running hot. The journal published a ridiculous number of around 1500 articles / year between 2020 and 2024. This is likely contributing to some of the systematic issues I am going to describe in this post. We have surpassed 600 articles for 2025 already & are on pace for a new record (and record profits!).
The triangle of trash
The journal Carbohydrate Polymers (IF 10.7) has a large overlap in content with two other infamous Elsevier-owned journals; one of which is the Journal of Ethnopharmacology (IF 4.8). Learn about the exquisite quality of research published in that journal in this great article by Parashorea tomantella, with some guest appearances by yours truly in the introduction:
Slipshod Self-service Ethnopharmacology
“Since Journal of Ethnopharmacology sees no reason to reject bear bile powder research like other scientific journals, that means you can expect to see anything there” – Parashorea tomentella
The other “partner” journal is The International Journal of Biological Macromolecules (IF 7.7), whose Editor-in-Chief is the British papermiller John F Kennedy (not the dead US president!). Two out of three founding editors of Carbohydrate Polymers are deceased, but one is still alive: the same John F Kennedy!
Today, Carbohydrate Polymers has three Editors-in-Chief: Tatiana Budtova of Mines ParisTech in France, Manuel Coimbra of University of Aveiro in Portugal, and Kevin J. Edgar of Virginia Tech in USA. Budtova replaced Kennedy when he retired, some time after celebrating the 40 year anniversary of his journal in 2022. Noteworthy, in his editorial Kennedy announced “strategies to avoid fraudulent publications“:
“However, developments of the EM [‘Editorial Manager’] system have had to build in safeguards which were unnecessary 40 years ago. Here I refer to the fact that paper factories now exist where you can buy a fictitious paper, including data and paper theft, and get it published. Unacknowledged authors were virtually unheard of, and plagiarism was a word not known to me. […]
Authors must be fully aware of, and obey, the rules of ethics in publishing to ensure that the development and portrayal of new research is truly accurate and trustworthy. […]
Much of the editorial work will be automated and the automatic scrutiny for plagiarism, duplication and data theft will be far more sophisticated. There will be security standards brought in to validate data, authors having to register their work with regulatory bodies as they progress it. Such would have the added benefit of ensuring that funding only goes to true research and not just repetition of the work of others but on different materials – a frequent occurrence with research at the moment.”
In reality, as soon as Kennedy heard of papermills, he started using them himself. Read the relevant sections in these articles:
In international affairs and paper mills
Alexander Magazinov would like you to meet an Iranian scholar named Ali Akbar Velayati.
Queen’s University Belfast fights Welsh Terrorism
“your scatter gun approach has undermind a process that is undertaken confidentially […] It is sad that you are determined to undermine people’s reputations in the way you do.” – Queen’s University of Belfast to Sholto David.
Carbohydrate Polymers (CP) has the highest impact factor among those three interconnected journals, and subsequently charges the highest fees for Open Access publishing ($5.340) – If you don’t care about Open Access, then publication is free, the same concept that is applied in the other two journals.
Exploring the “scientific” products between the three outlets, one finds a remarkable overlap in content (and authors). I have spent a bit of time over the past couple of months learning just how much (or rather how little) editorial oversight, diligence and integrity we can expect from such a reputable journal in the field of glycoscience.
Descending into the swamp
My deep-dive into CP started when I came across two articles (co-)authored by Tharwat Shaheen and Ali Hebeish from the National Research Centre in Cairo, Egypt.
- M.H. El-Rafie, Th.I. Shaheen , A.A. Mohamed, A. Hebeish Bio-synthesis and applications of silver nanoparticles onto cotton fabrics Carbohydrate Polymers (2012) doi: 10.1016/j.carbpol.2012.06.020
- M.H. El-Rafie, A.A. Mohamed, Th.I. Shaheen , A. Hebeish Antimicrobial effect of silver nanoparticles produced by fungal process on cotton fabrics Carbohydrate Polymers (2010) doi: 10.1016/j.carbpol.2009.12.028

The article reports different ppm conditions for the two figures. The overlap / reuse of this figure is not indicated or marked anywhere in the paper.
Another paper by same author was published already in 2016:
Mehrez E. El-Naggar , Tharwat I. Shaheen, Moustafa M.G. Fouda , Ali A. Hebeish Eco-friendly microwave-assisted green and rapid synthesis of well-stabilized gold and core–shell silver–gold nanoparticles Carbohydrate Polymers (2016) doi: 10.1016/j.carbpol.2015.10.003

Not exactly assuring, since it takes about 2 seconds to see this overlap when looking at the figure. And there is even more:

This paper and Mohamed et al. 2016 (DOI: 10.1016/j.ijbiomac.2016.10.082) contain the same images to represent different nanoparticles, published by largely the same authors in 2016
This very obvious editorial oversight made me wonder if anyone at this journal actually looks at a manuscript before it gets published. (Spoiler alert: I don’t think so). This is were the descend into the swamp begins.
Various sleuths have come across similar issues in CP articles over the years, but I don’t think anyone went through a part of the journals catalogue systematically. At the time of the publication of this post, I have flagged 139 articles in CP, almost all of which were published in or after 2020. I screened probably ~ 1000-1500 articles by eye. In some cases I complemented this by using ImageTwin.ai to scan images, which has been tremendously helpful, in particular to detect reuse of images in other articles (see above).
Double-blinded editors and reviewers
Some articles published in CP are so stupid, so atrociously bad, that I refuse to believe that anyone in the editorial office at CP or any reviewer has spent even a minute or two looking at these studies.
A good example to illustrate what I mean by that: A study from Iran, cited a whopping 181 times (according to Google Scholar):
Mahdi Rahimi, Ehsan Bahojb Noruzi, Elham Sheykhsaran, Baharin Ebadi, Zahra Kariminezhad, Morteza Molaparast, Mojtaba Ghanbari Mehrabani, Bahareh Mehramouz, Mehdi Yousefi, Raman Ahmadi, Bahman Yousefi, Khudaverdi Ganbarov, Fadhil S Kamounah, Vahid Shafiei-Irannejad, Hossein Samadi Kafil Carbohydrate polymer-based silver nanocomposites: Recent progress in the antimicrobial wound dressings Carbohydrate Polymers (2020) doi: 10.1016/j.carbpol.2019.115696

In case you were wondering what I meant by “the triangle of trash”: this entire Figure 5 was reproduced 1:1 from an Egyptian paper published by a different set of authors (including Ali Hebeish!), 4 years prior in the International Journal of Biological Macromolecules:
A.S. Montaser, A.M. Abdel-Mohsen, M.A. Ramadan, A.A. Sleem, N.M. Sahffie, J. Jancar, A. Hebeish Preparation and characterization of alginate/silver/nicotinamide nanocomposites for treating diabetic wounds International Journal of Biological Macromolecules (2016) doi: 10.1016/j.ijbiomac.2016.07.050
This figure went through two rounds of quality control, editorial evaluation, and reviews. Very confidence-inducing, right? Both papers displaying it have been cited 270 times combined. This abomination of a figure is so terribly bad, it would be funny if it didn’t show animals that were actively being harmed. The authors didn’t even have the decency to put in a minimum amount of effort; it’s a shame. I understand that some people think preserving the integrity of the scientific record is not about shaming individuals who make mistakes, but if I produced and published a figure like that, I would be ashamed. Let’s hope they fabricated the whole thing and never actually harmed these animals in the first place.
Moving on: This Chinese study had so many overlapping areas within and between figure 3 and 4 that ImageTwin basically ran out of distinct colours annotating all of the overlap (a first for me!).
Yifei Bai, Tingting Qiu, Bin Chen, Cheng Shen, Chengbing Yu, Zhen Luo, Jing Zhang, Weina Xu, Zilong Deng, Jianxiong Xu, Hongcai Zhang Formulation and stabilization of high internal phase emulsions: Stabilization by cellulose nanocrystals and gelatinized soluble starch Carbohydrate Polymers (2023) doi: 10.1016/j.carbpol.2023.120693


Given the extent of overlap I think we can be reasonably confident that this was not an accident so I won’t discuss what this paper is about since it’s probably made up anyway.
Moving on, you must understand that CP takes data availability very seriously. This is why in Lipatova & Losev, 2024 (from the Institute of the Russian Academy of Sciences) they provide not one, but two data availability statements contradicting each other:
I M Lipatova, N V Losev The influence of the combined impact of shear stress and cavitation on the structure and properties of starch-natural rubber composite Carbohydrate Polymers (2024) doi: 10.1016/j.carbpol.2024.121852
Parashorea tomantella provided some insights into these “No data was used for the research described in the article” statements in his article on the Journal of Ethnopharmacology. They make no sense, unless it’s an admission that the data is imaginary, perhaps? With Lipatova & Losev, we can assume the worst:
V.A. Burmistrov , I.M. Lipatova , N.V. Losev, J.A. Rodicheva , O.I. Koifman Influence of the composition and high shear stresses on the structure and properties of hybrid materials based on starch and synthetic copolymer Carbohydrate Polymers (2018) doi: 10.1016/j.carbpol.2018.05.056

Example No. 3: Overlapping panels in not 1, not 2, not 3, but 4 different figures:
Lisheng Zhou, Liming Zhou, Chengxiu Wei, Rui Guo A bioactive dextran-based hydrogel promote the healing of infected wounds via antibacterial and immunomodulatory Carbohydrate Polymers (2022) doi: 10.1016/j.carbpol.2022.119558
In Figure 5a, a 45° rotation of the control petri dish seems to turn “No Nir” into “Nir”.



Traditional Chinese Medicine (because of course!)
Every good, high quality Elsevier journal needs to publish sketchy studies about how Traditional Chinese Medicine (TCM) can cure cancer. CP is no exception.
This Chinese study states in its abstract: “Therefore, HA-Lip-HJB is a promising formulation for metastatic breast cancer therapy.” HJB is a compound from the herbaceous plant Euphorbia fischeriana Steud which is used for cancer treatment in TCM. They wrapped it in some modified liposomes coated with Hyaluronic acid, and voila, a breast cancer cure! They did an in vivo study with mice that they killed at the end, but didn’t think about providing any information on ethics approval. Given that all this is complete quackery, you also need to be creative with your figures to make TCM work:
Dan Liu, Qi Zhang, Jing Wang, Shuang Guan, Defu Cai, Jicheng Liu Inhibition of growth and metastasis of breast cancer by targeted delivery of 17-hydroxy-jolkinolide B via hyaluronic acid-coated liposomes Carbohydrate Polymers (2021) doi: 10.1016/j.carbpol.2020.117572

Obviously, TCM has all sorts of other great applications. Here, Chinese herbal medicine is combined with nanofibers (bullshit bingo!) as a wound dressing, Parashorea tomentella spotted this overlap in one of the figures:
Meng Zhang , Yinchuan Wang , Xueling Yin , Mei Xue , Xin Zhao , Runxiao Zheng, Jianfeng Qiu, Zhihong Zhu Chlorogenic acid-assisted dopamine‑sodium alginate composite nanofiber membranes for promoting wound healing Carbohydrate Polymers (2025) doi: 10.1016/j.carbpol.2025.123298

Once again, this study also does not mention any ethical guidelines or approval to do invasive in-vivo experiments in animals, but who cares, right? Certainly not Drs. Edgar, Coimbra and Budtova!
Chitosan everywhere, please help
In CP, Chitosan is the Swiss army knife for papermill crap. It’s everywhere, and it can do anything, including treatment of any medical condition under the sun.
A couple of examples:
Pei Wang , Zhi Peng , Yanyan Zhang , Xuejing Zhang , Xia Chen , Fan Li , Bo Chen , Shiwei Niu , Kaili Du , Li-Min Zhu A chitosan-camouflaged nanomedicine triggered by hierarchically stimuli to release drug for multimodal imaging-guided chemotherapy of breast cancer Carbohydrate Polymers (2024) doi: 10.1016/j.carbpol.2024.122073




Figure 6 is an absolute mess of overlapping panels. All other figures in this paper are also extremely cringe-worthy, as pointed out by me and various other people on PubPeer, who also raised concerns about “exceedingly large” tumours, raising “potential ethical issues regarding animal welfare”. The authors responded to half of the concerns in June 2024 stating:
“We re-examined our previous data graph and saved the corresponding original data folder and will contact the editor as soon as possible to correct the carelessness.“
How do you correct an article in which every figure has serious integrity issues (which must impact results and conclusions), you might ask? I can’t answer that, but I am sure the authors will be able to come up with some random story, and maybe (likely) CP will help them avoid a retraction, or maybe even a correction. I can assure you though that this crap won’t cure any cancer.
What with the Figures 2 and 9 of the next Chinese paper, I will never believe any editor or reviewer ever looked at this figure properly:
Xin Luo , Yidan Liu , Jianhui Pang , Shichao Bi , Zhongzheng Zhou , Zhe Lu , Chao Feng , Xiguang Chen , Ming Kong Thermo/photo dual-crosslinking chitosan-gelatin methacrylate hydrogel with controlled shrinking property for contraction fabrication Carbohydrate Polymers (2020) doi: 10.1016/j.carbpol.2020.116067

Here, the artistic abilities of the authors were put to good use:
Panpan Song, Bingjie Wang, Qi Pan, Tianze Jiang, Xiangyan Chen, Miao Zhang, Jiaojiao Tao, Xia Zhao GE11-modified carboxymethyl chitosan micelles to deliver DOX·PD-L1 siRNA complex for combination of ICD and immune escape inhibition against tumor Carbohydrate Polymers (2023) doi: 10.1016/j.carbpol.2023.120837




Just when the author Xia Zhao replied on PubPeer to promise a correction and to “sincerely apologize for the problems” which do “not affect the conclusions of this study”, Elisabeth Bik found much, much more:





I went back again and found this additional manipulation. Truly an artist:

Figure 1E, it seems like another portion of the inserted image consists of two identical but rotated images.
More art by the same first author Panpan Song – here some more Chitosan nanogel (lord help us) to target tumours in an ACS journal, again straight out of Photoshop:
Panpan Song, Nannan Song, Li Li, Minghao Wu, Zhongxia Lu, Xia Zhao Angiopep-2-Modified Carboxymethyl Chitosan-Based pH/Reduction Dual-Stimuli-Responsive Nanogels for Enhanced Targeting Glioblastoma Biomacromolecules (2021) doi: 10.1021/acs.biomac.1c00314

Several nanoparticles look remarkably similar
And because all good things come in threes, please enjoy another Panpan Song about Chitosan in the International Journal of Biological Macromolecules:
Panpan Song, Zhongxia Lu, Tianze Jiang, Wenwei Han, Xiangyan Chen, Xia Zhao Chitosan coated pH/redox-responsive hyaluronic acid micelles for enhanced tumor targeted co-delivery of doxorubicin and siPD-L1 International Journal of Biological Macromolecules (2022) doi: 10.1016/j.ijbiomac.2022.09.245

Ellipses of the same color highlight blue or green signals that look remarkably similar
For a change, how about some copy-pasted western-blots in this chitosan paper, from another lab in China. Get your bullshit-bingo card ready before reading its title:
Licong Yang, Yabin Wang , Zhiwei Li , Xiaohua Wu , Jingtao Mei , Guodong Zheng Brain targeted peptide-functionalized chitosan nanoparticles for resveratrol delivery: Impact on insulin resistance and gut microbiota in obesity-related Alzheimer’s disease Carbohydrate Polymers (2023) doi: 10.1016/j.carbpol.2023.120714


If you come across a chitosan-related paper in CP that is legit, please let me know. I could go on and on, I have a list of dozens of chitosan-related articles in CP with some sort of issue (spreadsheet), mostly image overlap. I will spare you those; it gets repetitive.
XRD patterns straight outta Photoshop
One regular CP contributor, Deng-Guang Yu, already recently featured prominently on For Better Science:
A stupid and foolish question
“Those noises have no scientific meanings, suggest nothing, forming no any judgments, and have no any influences on the experimental results. ” – Professor Deng‐Guang Yu
We discovered a few weeks ago that he seemingly recycled and manipulated XRD data in dozens (probably hundreds) of papers (in CP and elsewhere) between 2009 and 2025. But problems with XRD data in CP go far beyond Yu. XRD data is a very commonly used technique and I would estimate that it is used in around 1/3 of CP papers, at least. I found various articles with sketchy XRD patterns, but I was (not really) shocked to find the names of two current editors of Carbohydrate Polymers, Fengwei ‘David’ Xie (University of Nottingham Ningbo, China) and Fwu-Long Mi (Taipei Medical University, Taiwan) among those. Here is Xie:
Dongling Qiao, Yuchun Huang, Xinran Hou, Fayin Ye, Kao Wu, Fatang Jiang, Guohua Zhao, Binjia Zhang, Fengwei Xie Enhancing thermal stability and mechanical resilience in gelatin/starch composites through polyvinyl alcohol integration Carbohydrate Polymers (2024) doi: 10.1016/j.carbpol.2024.122528

XRD patterns in Figure 2 contain two pairs with identical noise, marked with the same shaded background by me:
And here is Mi:
Li-Ting Wu, I-Lin Tsai, Yi-Cheng Ho, Yu-Hao Hang, Chi Lin, Min-Lang Tsai, Fwu-Long Mi Active and intelligent gellan gum-based packaging films for controlling anthocyanins release and monitoring food freshness Carbohydrate Polymers (2021) doi: 10.1016/j.carbpol.2020.117410

(I marked identical spectra with shades of the same background).
However, both of these are far from being the worst XRD patterns I saw in CP.
Jawza Sh Alnawmasi (sole author) from Qassim University, Saudi Arabia published this masterpiece in CP in 2023. Given the lack of co-authors I think it’s fairly clear who is responsible for the artwork. I have marked some of the repeating noise patterns in Figure 3 below:
Jawza Sh Alnawmasi Construction of amino-thiol functionalized ion-imprinted chitosan for lead (II) ion removal Carbohydrate Polymers (2023) doi: 10.1016/j.carbpol.2023.120596


Alnawmasi is involved in questionable activities in other journals too. Here, for example, in the International Journal of Biological Macromolecules (You see why I termed it the “triangle of trash”):
Huda S. AlSalem, Raedah A.S. Alatawi, Abeer Abdulaziz H. Bukhari, Jawza Sh Alnawmasi, Imen Zghab, Mohamed G. El-Desouky, Meshal H. Almabadi, Zainab Hassan Alnakhli, Nadia H. Elsayed Adsorption and removal of Pb (II) via layer double hydroxide encapsulated with chitosan; synthesis, characterization adsorption isotherms, kinetics, thermodynamics, & optimization via Box-Behnken design International Journal of Biological Macromolecules (2024) doi: 10.1016/j.ijbiomac.2024.137517

In case you were wondering how many papermill buzzwords can fit into a paper title, here is a respectable attempt for a new high score, from Iran:
Zahra Amini, Sam Shekofte Rudsary, Seyed Sadegh Shahraeini, Babak Faraji Dizaji, Pouya Goleij, Ameneh Bakhtiari, Mohammad Irani, Fariborz Sharifianjazi Magnetic bioactive glasses/Cisplatin loaded-chitosan (CS)-grafted- poly (ε-caprolactone) nanofibers against bone cancer treatment Carbohydrate Polymers (2021) doi: 10.1016/j.carbpol.2021.117680

Not sure if these strange chitosan nanofibers are supposed to help against bone cancer or if they are made to prevent bone cancer treatment? Doesn’t matter, because for all I know, these things don’t exist anyway.
While we are talking about nanofibers, you can of course find your fair share of nano bullshit in CP, such as this paper from University of Palermo in Italy:
Annalisa Martorana, Giovanna Pitarresi, Fabio Salvatore Palumbo, Valentina Catania, Domenico Schillaci, Nicolò Mauro, Calogero Fiorica, Gaetano Giammona Fabrication of silver nanoparticles by a diethylene triamine-hyaluronic acid derivative and use as antibacterial coating Carbohydrate Polymers (2022) doi: 10.1016/j.carbpol.2022.119861

Extensive overlap in Figure 6 for rows representing different experimental conditions
“Internal quality control”
I am no by no means done going through all volumes of this journal – I only went back to 2020 and screened maybe 1/3 of the volumes published between 2021 and 2025, but the journal has been around since 1981; god knows when they abolished all editorial standards. But I have chitosan-nanofibers coated with hyaluronic acid wrapped in hydrogel coming out of my ears and I see XRD patterns in my sleep, so I will be taking a break before looking at more of this. Or maybe I should move on to a different journal? Let me know if you have suggestions (@academic-integrity.bsky.social on BlueSky); there is no shortage of potential candidates!
Cynicism aside and on a serious note, I want to reiterate that this can be fixed, should the publisher be willing to do so. The cracks in the editorial process at CP are clearly being abused by authors with questionable motives. One option: shut the whole thing down. They won’t do that because it’s a cash-cow, so I want to make two very obvious and realistic suggestions that no one asked for. Other journals which care about integrity and reproducibility of the papers they publish, have implemented in recent years various processes that helped tremendously and I promise, they don’t hurt:
- Read the damn paper and look at the figures before publishing it; it’s not that hard and a lot of these issues are painfully obvious by just looking at a figure for a few seconds. Using plagiarism tools and image analysis software is all fun and games and I am sure they are helpful, but it’s clearly not working (since CP uses multiple tools already but still publishes a lot of problematic papers). I used some of these tools (ImageTwin & Forensically) myself when looking at CP‘s catalogue, and they have been tremendously helpful in identifying problems, but they are just tools and should not replace your eyes; they are supposed to be complementary – you don’t drive a car with our eyes closed just listening to directions from your smartphone, do you?
- Require raw data to be deposited. CP is incredibly restrictive and intransparent, as are its two companion outlets and many other Elsevier journals. Some papers state that no data was used (what does that even mean??) and others say that data is available upon request. When I request data, no-one replies to my requests, ever.
Almost all of the papers I flagged are recent (published within 5 years), the data must still be available. I assume authors won’t send data when they know it will show anomalies (or when it doesn’t exist in the first place). They don’t face consequences from the journals for this practice so they just ignore requests. You can get rid of so many dubious papers by actually requiring a transparent dataset to be uploaded to a repository, such as FigShare. Other journals have implemented these policies and they have been very helpful. You can fake XRD patterns in Photoshop (clearly, as I have illustrated above), but it gets a lot harder when you have to deposit a matching raw data file.
Both of these approaches would help tremendously in cleaning up the journal. Do they care about scientific integrity at Elsevier? Probably not (not enough anyway), but who knows. I am a cynical postdoc, but sometimes also a naive optimist, maybe there is someone at CP who can make a difference and prove me wrong, but I won’t believe anyone’s promises until I see actual changes.
The Incorrigible Elsevier
“I woke up seeing Elsevier’s giant middle finger in front of my face.” – Mu Yang
Elsevier’s parent company RELX reported record profits for the last fiscal year so in their books everything is going great. They are indexing their own journals via Scopus, nobody can touch them.
Here is a spreadsheet with problematic CP papers:

Donate!
If you are interested to support my work, you can leave here a small tip of $5. Or several of small tips, just increase the amount as you like (2x=€10; 5x=€25). Your generous patronage of my journalism will be most appreciated!
€5.00




It is nice to see new sleuths.
LikeLiked by 2 people
Rebellion against Elsevier (in German – and, best of all, featuring IVAN ORANSKY 😆😆😆):
https://taz.de/Wissenschaftliche-Publikationen/!6071910/
LikeLike
Ivan is the go-to expert for everything and everyone!
LikeLike
I did a bit of a probe on PubPeer regarding that Rahimi “review” mentioned above, which is a travesty from beginning to end. Looks like these wankers are actually being protected by the powers that be at PubPeer, which are only allowing established sleuths to critique their abominably ridiculous outputs. It may be time to consider an alternative route for post-publication review. I don’t know what it is with PP, some sort of weird post-colonial guilt perhaps? We need to establish a genuine cordon sanitaire around scientific crap, or RFK and his minions will be over the wall with their torches afore long.
On another note, are you sure that papers that are not open access are published for free? I could not find this stated on the home pages of the journals in question.
LikeLike